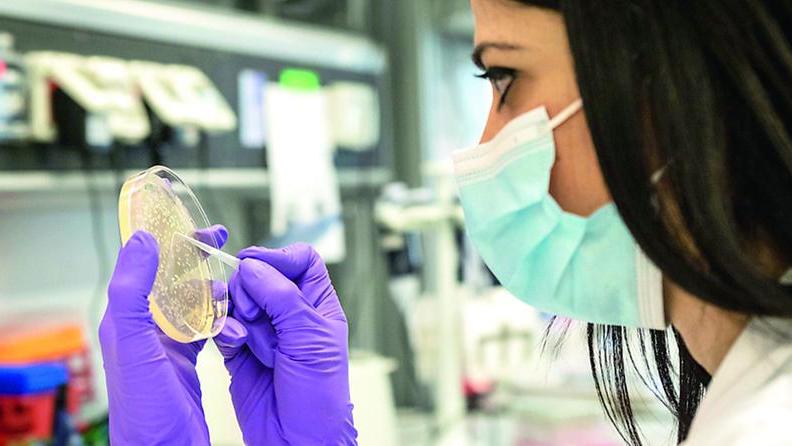
La pandemia silente, super-batteri resistenti agli antibiotici: «È emergenza globale»
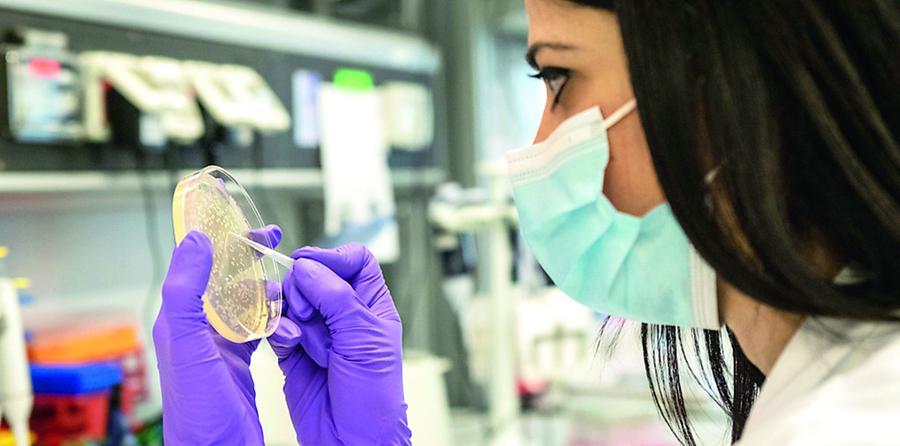
La pandemia silente, super-batteri resistenti agli antibiotici: «È emergenza globale»

T+
CONTENUTO RISERVATO AGLI ABBONATI
Sei già registrato / abbonato? ACCEDI
L’intervista
La pandemia silente, super-batteri resistenti agli antibiotici: «È emergenza globale»
di Cristiano Pellegrini
Rino Rappuoli direttore scientifico della Fondazione Biotecnopolo di Siena e coordinatore scientifico del MAD Lab presso Toscana Life Sciences : «Nel 2050 fino a dieci milioni di morti per la resistenza agli antibiotici».
1 MINUTI DI LETTURA
Nel 2014 uno studio inglese ha rivelato che il problema della resistenza agli antibiotici sta diventando molto grave. Dalla stima dei 700mila morti all'anno previsti nel mondo, se continuiamo così, nel 2050 avremo almeno 10 milioni di morti all’anno, che saranno più dei decessi causati dai tumori, circa 8 milioni. Nel 2022, inoltre, secondo un'altra analisi, i morti sono gi&agrav...